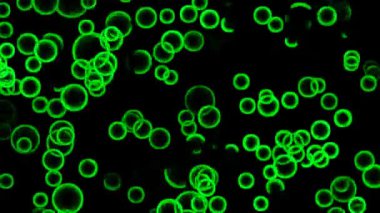
Yeşil soyut çemberler. Bu görüntüler bir sonraki kurgunda, projende ya da filminde harika görünecek. Projenizin üretim değerini bir seviye yükseltin.
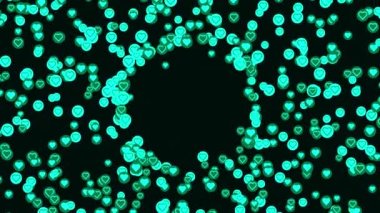
Kara deliğin, ilişki ve romantizm kavramının etrafında siyah arka planda kalan aşk kalpleri. Animasyon. Mavi ve yeşil Sevgililer Günü Sembolleri.

İhlal Bildirim Formu
En Çok Aranan Kelimeler
yeşilRenkMaviArkaplanRenkliRenderşekilSevgililer GünüparlakAydınlanmışAşkSoyutParlaIşıksiyahKoyuTurkuazsembolduyguFanteziefektHareketKaossimgekalptaşınıyorSihirÇabuk!birçokdöndürrasgeleDuygularyavaşSihirlidöndürmeanimasyonetrafındaSevgiDöngükonfetigenelindeCGIillüstrasyonloopablemaviler4 kBenzer İçerikler